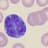
VariantLymph

Overview
- Steam
- 76561198015068034
- 4 Jul 2024 on 16th IR 1
- Total on servers
- 4 matches / 2 hours
- Matches
- Win rate
- Offense/defense score
- Combat/support score
Kills
- Total kills
- 17 (0.14 KPM)
- Kill types
- Total deaths
- 49 (0.39 DPM)
- Death types
- Overall K/D ratio
- 0.35
- Longest killstreak
- 3 kills on 16th IR 1 (4 Jul 2024)
- Most deaths to artillery
- 0 deaths on 16th IR 1 (4 Jul 2024)
Progression
Melee
- Melee kills
- 0 (N/A KD)
- Melee deaths
- 0
- N/A
- Current melee killstreak
- 0 melee kills (4 matches)
Recent matches played
- (0.16 kpm · 0.4 KD)
 Driel Off. GER ()
Driel Off. GER () - (0.15 kpm · 0.4 KD)
 Kursk Warfare (Night) ()
Kursk Warfare (Night) () - (0.12 kpm · 0.3 KD)
 Mortain Warfare ()
Mortain Warfare () - (0.06 kpm · 0.2 KD)
 Utah Beach Warfare ()
Utah Beach Warfare ()
Most kills matches
- (0.16 kpm · 0.4 KD)Most used: STG44
 Driel Off. GER ()
Driel Off. GER () - (0.15 kpm · 0.4 KD)Most used: PPSH 41 W/DRUM
 Kursk Warfare (Night) ()
Kursk Warfare (Night) () - (0.12 kpm · 0.3 KD)Most used: UNKNOWN
 Mortain Warfare ()
Mortain Warfare () - (0.06 kpm · 0.2 KD)Most used: M1 CARBINE
 Utah Beach Warfare ()
Utah Beach Warfare ()
Missing a match? Send us the CRCON scoreboard link on Discord and we'll add the server.
Most kills in one game
- Infantry
- 10 on 16th IR 1 (4 Jul 2024)
- Machine Gun
- N/A
- Sniper
- N/A
- Armor
- N/A
- Artillery
- N/A
Loading most killed...
Most played with
Loading most played with...
Most played servers
See how you stack up against other players on the 16th IR leaderboards.
16th IR leaderboards.
Most played game modes
- Warfare3
- Offensive1
Weapon usage
| STG44 | 52.94% 9 |
| PPSH 41 W/DRUM | 23.53% 4 |
| UNKNOWN | 11.76% 2 |
| M1 CARBINE | 5.88% 1 |
| KARABINER 98K | 5.88% 1 |